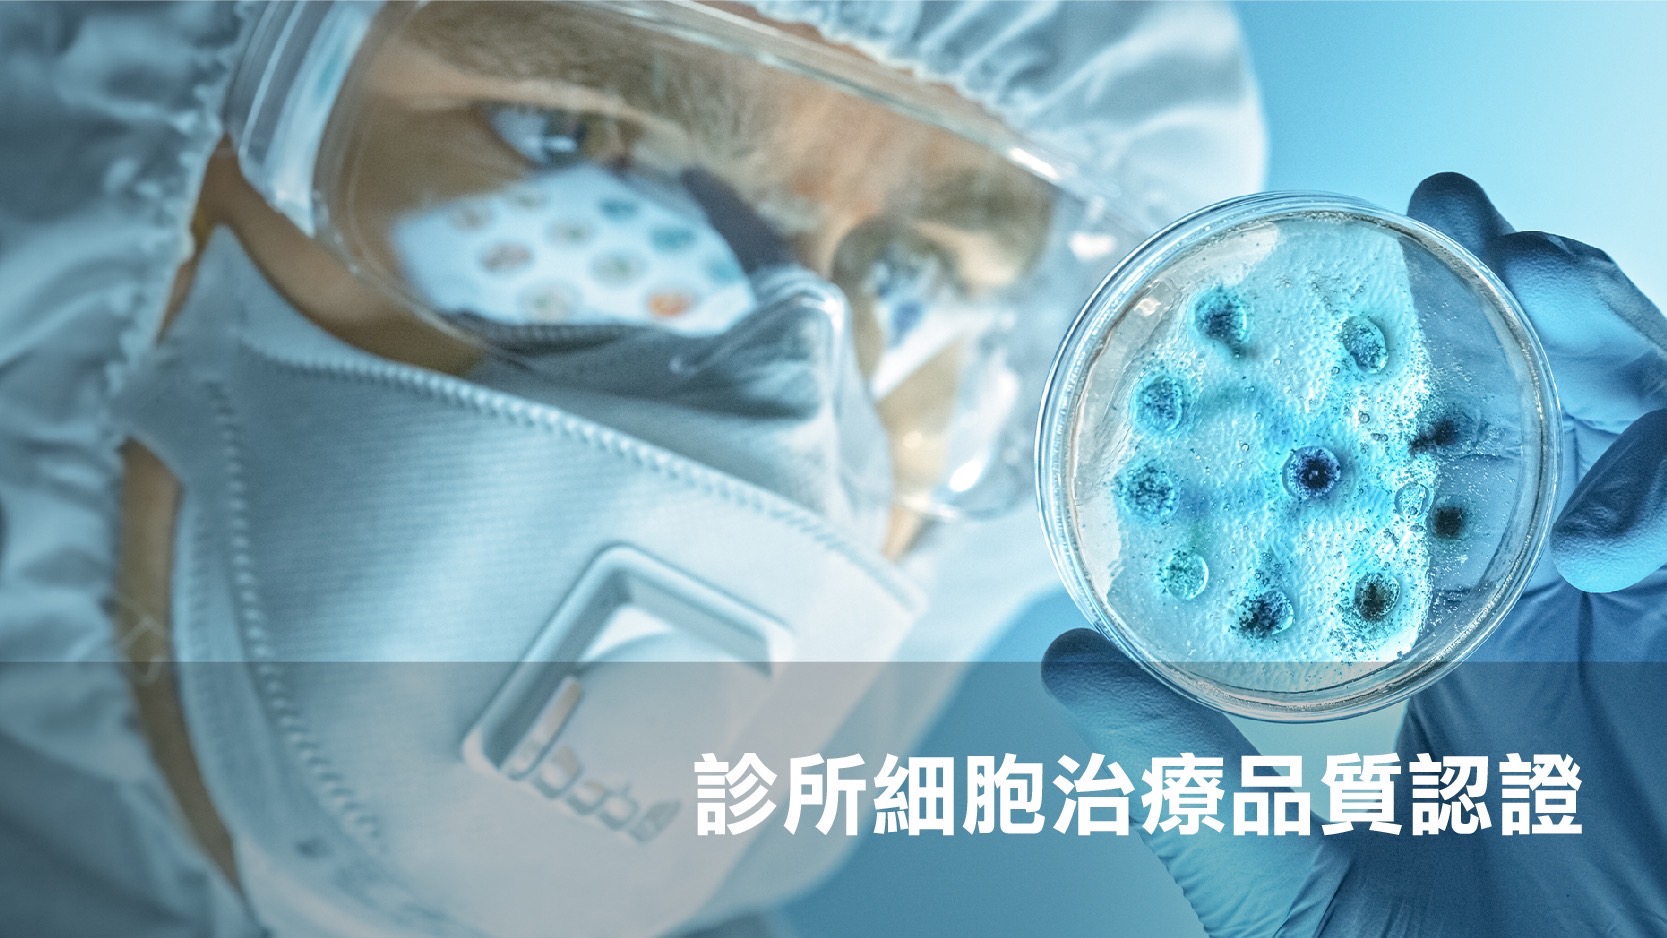

https://www.youtube.com/watch?v=ZtHl9whgp_g
【記者張品君/台中報導】今日,優妮診所宣布計畫成為台灣首批細胞治療特約診所,引領醫學美容進入全新視野。在這場訪談中,我們有幸與發言人熊元驥先生以及執行長范宗佑先生進行深入的交流。

細胞治療不是未來式,而是現在進行式

發言人熊元驥分享了細胞治療技術在國際上針對癌症、心臟病等領域已有亮眼的成績,且細胞治療為醫生和病患提供了更多治療選擇,同時激發了生技產業的發展。細胞治療是個趨勢,不管是重症病患或是日常醫美都是發展重點。熊元驥更說明,優妮診所已經開始為細胞治療世代作準備,診所細胞治療品質認證的審核是第一步,期望未來能成為中台灣細胞治療的先行者之一。
優妮診所的使命: 為每一位貴賓提供尊貴量身打造的醫美

優妮診所范宗佑執行長介紹診所使命,強調提供尊貴服務、打造舒適環境,結合優妮診所專業團隊和在光電美學、微整形與預防醫學的成熟技術,提供每位客戶擁有客製化、專業的醫美體驗。
隨著細胞治療技術的快速發展,診所須經醫策會通過診所細胞治療品質認證,始得向衛生福利部申請施行細胞治療技術。優妮診所也不落人後,積極參與此項計畫,包含24項查核項目,從機構運作到專業及安全的醫療照護作業進行全面審核。范宗佑執行長表示: 「為了確保病人安全及提升診所照護品質,希望優妮能夠以更強大、更專業、更高規格的服務來為社會大眾提供更好更完善的細胞治療相關項目,我們都非常期盼此項認證。」
細胞治療的脈動與優美診所的連結
在市場分析方面,范宗佑執行長指出,全球細胞療法市場預計到2028年將增長至321億美元,這顯示優妮診所將迎來一個快速增長的醫學美容市場。范宗佑執行長強調了細胞治療的未來趨勢,包括幹細胞應用、外泌體技術和客製化醫美體驗。為此,優妮診所和三顧有限公司合作,看好三顧為全台唯一通過GMP的細胞製備工廠,給予客戶安全的最高規格。合作推動自體纖維母細胞治療,為客戶提供針對皮膚缺陷更有效自然的選擇。

優妮診所未來將擴建二樓醫療使用空間、增設外科手術室,遵從衛生福利部的法規,確保醫療設施達到高標準,提供更多醫學美容的服務。范宗佑執行長說道: 「優妮診所將站在細胞治療的前沿,為客戶提供更安全、更有效的美容解決方案,並透過大數據分析和人工智慧打造客製化的醫美體驗。」

結語
這次訪談讓我們深入了解了優妮診所的使命、計畫和未來展望。優妮診所正以全新的姿態迎接細胞治療,為台灣醫美帶來更多創新和發展。我們期待看到,優妮診所將如何引領台灣醫學美容進入新的紀元。
